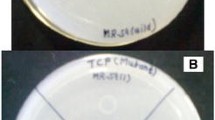

Abstract
Kosakonia radicincitans GXGL-4A, a gram-negative nitrogen-fixing (NF) bacterial strain is coated with a thick capsulatus on the surface of cell wall, which becomes a physical barrier for exogenous DNA to enter the cell, so the operation of genetic transformation is difficult. In this study, an optimized Tn5 transposon mutagenesis system was established by using a high osmotic HO-1 medium combined with the electroporation transformation. Eventually, a mutant library containing a total of 1633 Tn5 insertional mutants were established. Of these mutants, the mutants M81 and M107 were found to have an enhanced capability to synthesize siderophore through the CAS agar plate assay and the spectrophotometric determination. The bacterial cells of two mutants were applied in cucumber growth-promoting experiment. Cucumber seedlings treated with M81 and M107 cells had a significant increase in biomass including seedling height, seedling fresh weight, root fresh weight, and root length. The whole genome sequencing of the mutants M81 and M107 showed that the integration sites of Tn5 transposon element were located in MmyB-like helix-turn-helix transcription regulator (locus tag: A3780_19720, trX) and aminomethyltransferase-encoding genes (locus tag: A3780_01680, amt) in the genome of GXGL-4A, respectively. The ability of siderophore synthesis of the target mutants was improved by Tn5 insertion mutagenesis, and the mutants obtained showed a good plant growth-promoting effect when applied to the cucumber seedlings. The results suggest that the identified functional genes regulates the biosynthesis of siderophore in azotobacter GXGL-4A, and the specific mechanism needs to be further investigated.





Similar content being viewed by others
Data Availability
The whole genomic sequence of nitrogen-fixing bacterium GXGL-4A has been deposited in GenBank database, and the nucleotide sequences of trX and amt genes mentioned in this study are available under the genomic accession number CP015113. The mutants M81 and M107 have been stored in the China General Microbiological Culture Collection Center (CGMCC) with the preservation numbers CGMCC 24400 and CGMCC 24401, respectively.
Code Availability
Not applicable.
References
Hu D, Li S, Li Y, Peng J, Wei X, Ma J, Zhang C, Jia N, Wang E, Wang Z (2020) Streptomyces sp. strain TOR3209: a rhizosphere bacterium promoting growth of tomato by affecting the rhizosphere microbial community. Sci Rep 10:20132
Lian T, Huang Y, Xie X, Huo X, Shahid MQ, Tian L, Lan T, Jin J (2020) Rice SST variation shapes the rhizosphere bacterial community, conferring tolerance to salt stress through regulating soil metabolites. Systems 5(6):e00721-20
Verma P, Yadav AN, Khannam KS, Mishra S, Kumar S, Saxena AK, Suman A (2019) Appraisal of diversity and functional attributes of thermotolerant wheat associated bacteria from the peninsular zone of India. Saudi J Biol Sci 26:1882–1895
Sukweenadhi J, Koh SC, Yang DC, Balusamy SR, Kim Y-J, Lee CH (2018) A growth-promoting bacteria, Paenibacillus yonginensis DCY84(T) enhanced salt stress tolerance by activating defense-related systems in Panax ginseng. Front Plant Sci 9:813
Chen Y, Huang Z, Li J, Su G, Feng B (2020) Complete genome sequence of Kosakonia radicincitans GXGL-4A, a nitrogen-fixing bacterium with capability to degrade TEX. Curr Microbiol 77:1848–1857
Schalk IJ, Mislin GL, Brillet K (2012) Structure, function and binding selectivity and stereoselectivity of siderophore-iron outer membrane transporters. Curr Top Membr 69:37–66
Boukhalfa H, Crumbliss AL (2002) Chemical aspects of siderophore mediated iron transport. Biometals 15:325–339
Cornelis P, Matthijs S (2002) Diversity of siderophore-mediated iron uptake systems in fluorescent pseudomonads not only pyoverdines. Environ Microbiol 4:787–798
Meyer JM, Geoffroy VA, Baida N, Gardan L, Izard D, Lemanceau P, Achouak W, Palleroni NJ (2002) Siderophore typing, a powerful tool for the identification of fluorescent and nonfluorescent pseudomonads. Appl Environ Microbiol 68:2745–2753
Yang L, Nilsson M, Gjermansen M, Givskov M, Tolker-Nielsen T (2009) Pyoverdine and PQS mediated subpopulation interactions involved in Pseudomonas aeruginosa biofilm formation. Mol Microbiol 74:1380–1392
Meyer JM, Neely A, Stintzi A, Georges C, Holder IA (1996) Pyoverdin is essential for virulence of Pseudomonas aeruginosa. Infect Immun 64:518–523
Auerswald EA, Ludwig G, Schaller H (1981) Structural analysis of Tn5. Cold Spring Harb Symp Quant Biol 45:107–113
Pierson LS, Thomashow LS (1992) Cloning and heterologous expression of the phenazine biosynthetic locus from Pseudomonas aureofaciens 30–84. Mol Plant Microbe Interact 5:330–339
Christine B, Sandra M, Theresa P, Pierre C (2001) Impact of mutations in hemA and hemH genes on pyoverdine production by Pseudomonas fluorescens ATCC17400. FEMS Microbio Lett 205(1):57–63
Mellgren EM, Kloek AP, Kunkel BN (2009) Mqo, a tricarboxylic acid cycle enzyme, is required for virulence of Pseudomonas syringae pv. tomato strain DC3000 on Arabidopsis thaliana. J Bacteriol 191:3132–3141
Skitchenko RK, Usoltsev D, Uspenskaya M, Kajava AV, Guskov A (2020) Census of halide-binding sites in protein structures. Bioinformatics 36:3064–3071
Wang H, Xu M, Kong Q, Sun P, Yan F, Tian W, Wang X (2017) Research and progress on CIC-2 (Review). Mol Med Rep 16:11–22
Ruiz L, Motherway MO, Lanigan N, Dv S (2013) Transposon mutagenesis in Bifidobacterium breve: construction and characterization of a Tn5 transposon mutant library for Bifidobacterium breve UCC2003. PLoS ONE 8(5):e64699
Luan SL, Chaudhuri RR, Peters SE, Mayho M, Weinert LA, Crowther SA, Wang J, Langford PR, Rycroft A, Wren BW, Tucker AW, Maskell DJ (2013) Generation of a Tn5 transposon library in Haemophilus parasuis and analysis by transposon-directed insertion-site sequencing (TraDIS). Vet Microbiol 166(3–4):558–566
Sahu GK, Sindhu SS (2011) Disease control and plant growth promotion of green gram by siderophore producing Pseudomonas sp. Res J Microbiol 6(10):735–749
Chaiharn M, Chunhaleuchanon S, Lumyong S (2009) Screening siderophore producing bacteria as potential biological control agent for fungal rice pathogens in Thailand. World J Microbiol Biotechnol 25:1919–1928
Muthuselvan I, Balagurunathan R (2013) Siderophore production from Azotobacter sp. and its application as biocontrol agent. Int J Cur Res Rev 5(11):30–42
Louden BC, Haarmann D, Lynne AM (2011) Use of blue agar CAS assay for siderophore detection. J Microbiol Biol Educ 12(1):51–53
Machuca A, Milagres AMF (2003) Use of CAS-agar plate modified to study the effect of different variables on the siderophore production by Aspergillus. Lett Appl Microbiol 36(3):177–181
Schwyn B, Neilands JB (1987) Universal chemical assay for the detection and determination of siderophores. Anal Biochem 160:47–56
Byers DM, Gong H (2007) Acyl carrier protein: structure-function relationships in a conserved multifunctional protein family. Biochem Cell Biol 85(6):649–662
Zhao LN, Kaldis P (2020) Cascading proton transfers are a hallmark of the catalytic mechanism of SAM-dependent methyltransferases. FEBS Lett 594(13):2128–2139
Rudenko AY, Mariasina SS, Sergiev PV, Polshakov VI (2022) Analogs of S-adenosyl-l-methionine in studies of methyltransferases. Mol Biol 56:229–250
Kai B, Simon S, Alexander MK, Zach C-P, van Gilles P, Marnix HM, Tilmann W (2021) antiSMASH 60: improving cluster detection and comparison capabilities. Nucleic Acids Res 49(1):W29–W35
Wang W, Qiu Z, Tan H, Cao L (2014) Siderophore production by Actinobacteria. Biometals 27:623–631
Niehus R, Picot A, Oliveira NM, Mitri S, Foster KR (2017) The evolution of siderophore production as a competitive trait. Evolution 71(6):1443–1455
Banin E, Vasil ML, Greenberg EP (2005) Iron and Pseudomonas aeruginosa biofilm formation. Proc Natl Acad Sci USA 102:11076–11081
Porcheron G, Habib R, Houle S, Caza M, Lépine F, Daigle F, Massé E, Dozois CM (2014) The small RNA RyhB contributes to siderophore production and virulence of uropathogenic Escherichia coli. Infect Immun 82(12):5056–5068
Sahebi M, Tarighi S, Taheri P (2021) The Arac-like transcriptional regulator YqhC is involved in pathogenicity of Erwinia amylovora. J Appl Microbiol 00:1–11
Martínez-Granero F, Redondo-Nieto M, Vesga P, Martín M, Rivilla R (2014) AmrZ is a global transcriptional regulator implicated in iron uptake and environmental adaption in P. fluorescens F113. BMC Genomics 15:237
Glatt H (2000) Sulfotransferases in the bioactivation of xenobiotics. Chem Biol Interact 129:141–170
Acknowledgements
The authors thank professor Gong-You Chen (Shanghai Jiao Tong University) for his constructive discussion on experimental design.
Funding
This work was financially supported by the National Natural Science Foundation of China (Grant No. 31870496).
Author information
Authors and Affiliations
Contributions
The establishments of Tn5 transposon mutagenesis system and mutant library were carried out by BYF. The screening and identification of mutants were conducted by MTZ and GXS, and the qRT-PCR and Phylogenetic analysis were completed by YQB. The plant growth promotion experiment, CAS agar plate assay and data analysis were performed by YX and BYF. YPC conceived, designed, and supervised the whole project.
Corresponding author
Ethics declarations
Conflict of interest
The authors declare that they have no conflict of interest.
Ethics Approval
Not applicable.
Consent to Participate
Not applicable.
Consent for Publication
Not applicable.
Additional information
Publisher's Note
Springer Nature remains neutral with regard to jurisdictional claims in published maps and institutional affiliations.
Supplementary Information
Below is the link to the electronic supplementary material.
Fig. S1
Morphology of the NFB GXGL-4A cultured in different media (17500×). a LB (10 g/L NaCl); b LB (15 g/L NaCl); c HO-2 (7.5 g/L CaCl2). Supplementary file2 (TIF 1595 KB)
Fig. S2
Quantitative PCR (qRT-PCR) analysis of the target genes in mutants M81 a and M107 b The rpoB gene of GXGL-4A was used as an internal reference gene. Relative transcriptional levels of the target genes were calculated relative to rpoB using the ΔΔCT method, where CT is the threshold cycle. Double asterisks indicate that there is an extremely significant difference in transcription level between two samples (p<0.01), and a single asterisk denotes a significant difference in transcription level between two samples (p<0.05). The bars in diagrams mean standard deviations (SD). Analysis of variance (ANOVA) was conducted based on the data from three replicates using the software IBM SPSS Statistics (version 17.0). Supplementary file3 (PNG 14 KB)
Fig. S3
Transcriptional levels of four functional genes, sdm a, acps b, bks c and atpbp d flanking the Tn5 transposon integration sites of the mutants M81 and M107. The bars mean standard deviations (SD) in these diagrams, and the analysis of variance (ANOVA) was carried out based on the data from three duplications using the software IBM SPSS Statistics (version 17.0). Supplementary file5 (TIF 11 KB)
Fig. S4
PCR cloning of the trX and amt genes in the genome of GXGL-4A. M: DNA marker DL2000; Lane 1, PCR amplicon of the trX gene; Lane 2, PCR amplicon of the amt gene. Supplementary file9 (TIF 437 KB)
Fig. S5
CAS agar plate test in the functional complementarity and gene overexpression experiments. a the mutant M81 and original strain GXGL-4A; b the mutant M107 and original strain GXGL-4A; c the diameters of siderophore rings produced by the cells of GXGL-4A, 4A::trX and M81::trX (cm); d the diameters of siderophore rings produced by the cells of GXGL-4A, 4A::amt and M107::amt (cm). All the experiments were duplicated three times. Supplementary file10 (TIFF 2320 KB)
Fig. S6
The phylogenetic relationship between K. radicincitans GXGL-4A and other Kosakonia or Escherichia coli strains. The phylogenetic trees were constructed based on the nucleotide acid sequences of trX a and amt b genes by using the Neighbor-Joining method. The bootstrap consensus tree inferred from 2000 replicates is taken to represent the evolutionary history of the taxa analyzed. Branches corresponding to partitions reproduced in less than 50% bootstrap replicates are collapsed. The percentage of replicate trees in which the associated taxa clustered together in the bootstrap test (2000 replicates) are shown next to the branches. The evolutionary distances were computed using the Maximum Composite Likelihood method and are in the units of the number of base substitutions per site. Evolutionary analyses were conducted in MEGA7. T: type strain; E: the genus Escherichia; K: the genus Kosakonia. Supplementary file14 (PNG 27 KB)
Fig. S7
Growth curve comparison of the mutants M81, M107 and the wild-type strain GXGL-4A. The experiment was repeated three times. Supplementary file16 (PNG 21 KB)
Rights and permissions
Springer Nature or its licensor holds exclusive rights to this article under a publishing agreement with the author(s) or other rightsholder(s); author self-archiving of the accepted manuscript version of this article is solely governed by the terms of such publishing agreement and applicable law.
About this article
Cite this article
Feng, BY., Zhang, MT., Su, GX. et al. Siderophore Synthesis Ability of the Nitrogen-Fixing Bacterium (NFB) GXGL-4A is Regulated at the Transcriptional Level by a Transcriptional Factor (trX) and an Aminomethyltransferase-Encoding Gene (amt). Curr Microbiol 79, 369 (2022). https://doi.org/10.1007/s00284-022-03080-4
Received:
Accepted:
Published:
DOI: https://doi.org/10.1007/s00284-022-03080-4